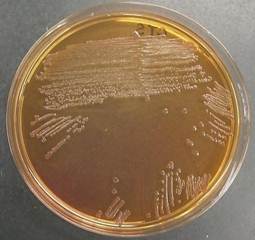

印刷
ページ番号:4302
更新日:2026年2月27日
ここから本文です。
細菌担当
細菌担当
食品の細菌検査
食品衛生法に基づき保健所が収去した食品の細菌検査や食品製造・流通業者等から依頼を受けた食品等の細菌検査を行っています。

食中毒発生時の細菌検査
症状や潜伏時間から想定される食中毒起因菌を主な対象として、患者の便や吐物・食品等の細菌検査を行っています。また必要な場合には、免疫学的検査や遺伝子検査を実施し、検出された細菌の病原性の確認や感染源の解明に役立てています。

パルスフィールドゲル電気泳動装置

電気泳動画像
感染症法に係わる細菌検査
感染症法に定められた感染症(細菌性赤痢、腸管出血性大腸菌感染症など)の発生に伴い、接触者や関係者の細菌検査を行います。他にも、結核菌の遺伝子解析及びカルバペネム耐性腸内細菌目細菌(CRE)などの薬剤耐性菌の遺伝子解析を行っています。
腸管出血性大腸菌O157
浴槽水の細菌検査
公衆浴場法施行条例等に基づいた浴槽水のレジオネラ属菌等の検査を行っています。また、県民や事業者から依頼を受け浴槽水等の水質検査を行っています。